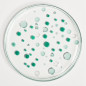
Patyka –  Lotion Purifiante Perfectrice, 200 ml

- Nouveau

Livraison offerte en point relais à partir de 39€ d'achat en France Métropolitaine
Livraison offerte en point relais à partir de 39€ d'achat en France Métropolitaine
La Lotion Purifiante Perfectrice de Patyka est un soin quotidien sans alcool, spécialement formulé pour les peaux normales à mixtes sujettes aux brillances, pores dilatés et imperfections récurrentes.
La Lotion Purifiante Perfectrice de Patyka est un soin quotidien sans alcool, spécialement formulé pour les peaux normales à mixtes sujettes aux brillances, pores dilatés et imperfections récurrentes.
Sa texture fraîche et légère agit comme une passerelle entre le nettoyage et l’hydratation, en préparant parfaitement la peau à recevoir les soins.
Elle associe un trio d’actifs purifiants puissants :
2 % de PHA (Gluconolactone) : exfolie en douceur et affine le grain de peau.
Gluconate de zinc : régule les imperfections.
Extrait de mélisse bio : apaise et équilibre la peau.
Enrichie en vinaigre de pomme bio, reconnu pour ses vertus astringentes et rééquilibrantes, elle resserre les pores, limite leur obstruction et affine visiblement le grain de peau, sans agresser ni dessécher.
Utilisée après la Gelée Nettoyante Purifiante, elle laisse la peau nette, moins brillante, plus uniforme et apaisée.
Efficacité prouvée
Dès 1 jour : 90 % des pores resserrés, 100 % d’excès de sébum réduit.
Dès 7 jours : 90 % de texture de peau améliorée, 90 % de boutons rouges et blancs atténués.
Conseils d’utilisation
Appliquer matin et/ou soir après le nettoyage.
Utiliser à l’aide d’un coton ou directement avec les mains, sur l’ensemble du visage.
Indication : Lotion purifiante quotidienne – peaux normales à mixtes sujettes aux imperfections.
Labels et certifications
100 % du total est d’origine naturelle
40,1 % des ingrédients sont issus de l’Agriculture Biologique
COSMOS ORGANIC certifié par Ecocert Greenlife
COMPOSITION (FORMULE INCI)
AQUA (WATER), MENTHA VIRIDIS (SPEARMINT) LEAF EXTRACT*, PENTYLENE GLYCOL, GLUCONOLACTONE, ZINC GLUCONATE, GLYCERIN, SODIUM HYDROXIDE, LEVULINIC ACID, PARFUM (FRAGRANCE), SODIUM LEVULINATE, HYDROGENATED STARCH HYDROLYSATE, VINEGAR, SUCROSE LAURATE, ALOE BARBADENSIS LEAF JUICE POWDER*, CITRIC ACID, MELISSA OFFICINALIS LEAF EXTRACT*, CARVONE**, VANILLIN** [05-004-1.18]
*Ingrédients issus de l’Agriculture Biologique
**Constituants naturels de la composition aromatique